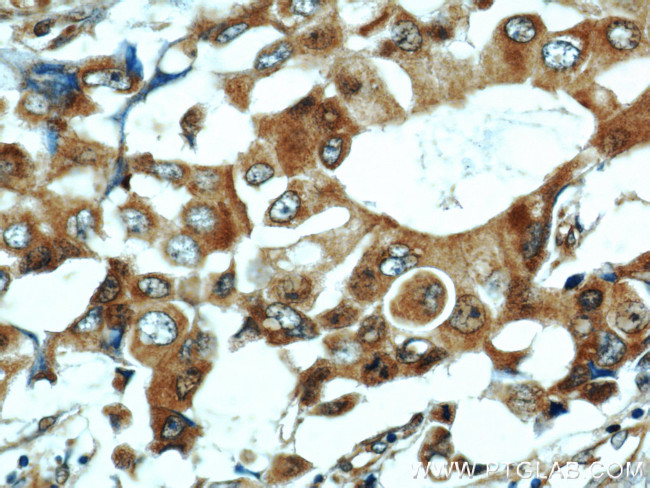
COX7A2L Antibody in Immunohistochemistry (Paraffin) (IHC (P))

Search
Proteintech
COX7A2L Polyclonal Antibody
{{$productOrderCtrl.translations['antibody.pdp.commerceCard.promotion.promotions']}}
{{$productOrderCtrl.translations['antibody.pdp.commerceCard.promotion.viewpromo']}}
{{$productOrderCtrl.translations['antibody.pdp.commerceCard.promotion.promocode']}}: {{promo.promoCode}} {{promo.promoTitle}} {{promo.promoDescription}}. {{$productOrderCtrl.translations['antibody.pdp.commerceCard.promotion.learnmore']}}
产品信息
11416-1-AP
种属反应
已发表种属
宿主/亚型
分类
类型
抗原
偶联物
形式
浓度
规格
纯化类型
保存液
内含物
保存条件
运输条件
产品详细信息
Immunogen sequence: MYYKFSGFT QKLAGAWASE AYSPQGLKPV VSTEAPPIIF ATPTKLTSDS TVYDYAGKNK VPELQKFFQK ADGVPVYLKR GLPDQMLYRT TMALTVGGTI YCLIALYMAS QPKNK (1-114 aa encoded by BC007095)
靶标信息
The cytochrome c oxidase (COX) family of proteins function as the final electron donor in the respiratory chain to drive a proton gradient across the inner mitochondrial membrane, ultimately resulting in the production of water. The mammalian COX apoenzyme is a dimer, with each monomer consisting of 13 subunits, some of which are mitochondrial and some of which are nuclear. COX7a2 (cytochrome c oxidase subunit VIIa polypeptide 2), also known as COX7AL or COX7AL1, is an 83 amino acid protein that localizes to the inner mitochondrial membrane and exists as a component of the COX complex, playing an important role in electron transport. COX7a2L (cytochrome c oxidase subunit 7A-related protein), also known as COX7AR or COX7RP, is an inner mitochondrial membrane protein that consists of 114 amino acids and is induced by estrogen.
仅用于科研。不用于诊断过程。未经明确授权不得转售。
生物信息学
蛋白别名: COX7a-related protein; COX7A2L; COX7AH; Cytochrome c oxidase subunit 7A-related protein; cytochrome c oxidase subunit 7A-related protein, mitochondrial; Cytochrome c oxidase subunit 7A2-like, mitochondrial; cytochrome c oxidase subunit VII-related protein; cytochrome c oxidase subunit VIIa polypeptide 2 like; Cytochrome c oxidase subunit VIIa-related protein; EB1; estrogen receptor binding CpG island; silica-induced gene 81 protein; Supercomplex assembly factor 1; supercomplex assembly factor I; unnamed protein product
基因别名: COX7A2L; COX7AR; COX7RP; EB1; SCAF1; SCAFI; SIG-81; SIG81; Silg81
UniProt ID: (Human) O14548, (Mouse) Q61387
Entrez Gene ID: (Human) 9167, (Rat) 298762, (Mouse) 20463